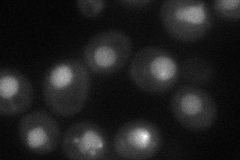
YOR242C
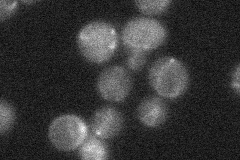
YOR242C
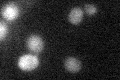
YOR242C

View description
Sporulation specific protein that localizes to the spore wall; required for sporulation at a point after meiosis II and during spore wall formation; SSP2 expression is induced midway in meiosis
Localization:
Intensity:
Fold change:
Significance:
-
C’ GFP library in SD

below threshold13.11 -
N' NOP1pr-GFP in SD
punctate,nucleus41.094 -
N' TEF2pr-mCherry in SD

nucleus7.10111 -
N' NATIVEpr-GFP in SD
below threshold18.3824 -
N' TEF2pr-VC and Cyto-VN in SD

below threshold23.0281 -
C’ GFP library in SD+DTT

cytosol15.751.2No -
C’ GFP library in SD+H2O2

cytosol18.261.39No -
C’ GFP library in Starvation Media
cytosol27.352.08No -
C’ GFP library on the background of Pup2-DaMP

below threshold -
C’ GFP library on the background of CCT mutant

below threshold16.71671.27389No
